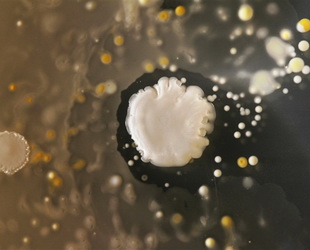

Dass unzählige Bakterien auf unseren Handys leben, ist keine neue Nachricht. Es ist aber immer wieder beeindruckend, wenn man einen Blick auf die "wuselige Szene" werfen kann. Vor kurzem haben einige Studenten der Fakultät für Molekularbiologie an der University of Surrey ein Experiment durchgeführt, bei dem sie eine Probe der Bakterien auf ihren Handys nahmen und unter dem Mikroskop betrachteten. Daraus ergaben sich die nun folgenden Bilder. Nach Angaben der Fachleute leben auch zahlreiche schädliche Bakterien, wie zum Beispiel Staphylococcus aureus, auf den Handys.